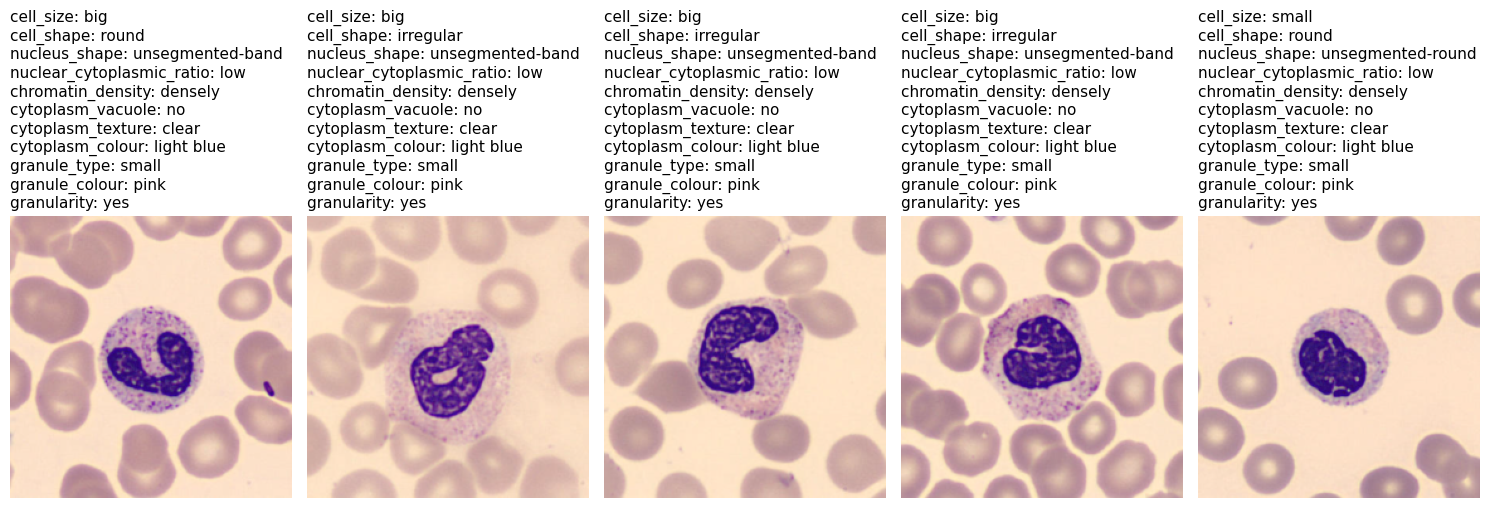
Refer to caption

AttriGen: Automated Multi-Attribute Annotation for Blood Cell Datasets
Abstract
We introduce AttriGen, a novel framework for automated, fine-grained multi-attribute annotation in computer vision, with a particular focus on cell microscopy where multi-attribute classification remains underrepresented compared to traditional cell type categorization. Using two complementary datasets: the Peripheral Blood Cell (PBC) dataset containing eight distinct cell types and the WBC Attribute Dataset (WBCAtt) that contains their corresponding 11 morphological attributes, we propose a dual-model architecture that combines a CNN for cell type classification, as well as a Vision Transformer (ViT) for multi-attribute classification achieving a new benchmark of 94.62% accuracy. Our experiments demonstrate that AttriGen significantly enhances model interpretability and offers substantial time and cost efficiency relative to conventional full-scale human annotation. Thus, our framework establishes a new paradigm that can be extended to other computer vision classification tasks by effectively automating the expansion of multi-attribute labels.
I Introduction
Leukemia caused 309,006 deaths in 2018, ranking 11th among cancer mortalities worldwide [1]. Early diagnosis hinges on microscopic review of blood smears, a task that is slow, labor-intensive, and increasingly hampered by shortages of laboratory experts [2, 3]. Although digital pathology promises relief, most automated systems still focus on coarse cell‐type classification, overlooking the fine-grained morphological cues that guide clinical decisions [4].
We bridge this gap with a dual-model architecture that mirrors the pathologist’s workflow: (1) a CNN trained on the PBC dataset [5] distinguishes eight leukocyte classes, and (2) a Vision Transformer (ViT) trained on WBCAtt [6] predicts eleven expert-defined attributes. The fused output yields a 12-attribute profile—cell type plus eleven morphology traits—providing a richer, clinic-aligned characterization.
To scale this capability, we introduce AttriGen, an automated annotation pipeline that applies the dual model to unlabeled images, producing high-quality multi-attribute labels with minimal human intervention. At 94.62% accuracy—near human expert performance—AttriGen annotates datasets orders of magnitude faster than manual review, allowing rapid dataset expansion and accelerating downstream model development.
Our main contributions are:
-
•
A hybrid CNN–ViT framework that unifies cell-type and attribute recognition for comprehensive WBC analysis.
-
•
AttriGen, an automated pipeline that generates clinically consistent, multi-attribute annotations at scale.
-
•
An empirical study of accuracy–time trade-offs, demonstrating substantial efficiency gains without clinically significant loss in precision.
II Related Work
II-A Blood Cell Analysis
II-B Evolution of Automated Blood Cell Analysis
II-C Attribute Recognition in Medical Imaging
Attribute-based recognition decomposes images into interpretable traits [12]. Beyond hematology, it has improved lung CT classification [13]. In blood cells, progress was limited until the WBCAtt dataset with 11 morphological attributes became available [6]. WBCAtt enabled P4BC (ACAcc 63.6 %) and ConceptCLIP (AUC 99.5%) [14, 15]. Earlier datasets such as PBC offered only coarse cell labels [5].
II-D Multi-Model Medical Imaging
Combining models boosts robustness. Ensembles of pre-trained networks outperform single models in breast histopathology [16], while multi-task CNNs simultaneously detect regions and classify bone‐marrow cells, achieving 97% ROI accuracy [17].

II-E Automated Dataset Annotation
Modern annotation pipelines cut labeling cost through semi-supervision and synthetic data. FixMatch attains 94.9% on CIFAR-10 with 250 labels by pseudo-labeling [18]. Domain-randomized synthetic images further reduce manual effort and rival real-data training [19]. Despite these advances, such techniques have been mostly applied to single-label classification tasks, with limited exploration in multi-attribute classification. This presents a significant challenge for domains like cell microscopy, where comprehensive morphological characterization requires multiple interdependent attributes to be annotated simultaneously; a gap that our proposed AttriGen framework addresses.
III Methodology
III-A System Architecture
Our system employs a dual-model architecture that processes blood cell images through two parallel pathways, as illustrated in Figure 1. This design leverages the complementary strengths of different deep learning architectures while capitalizing on the specialized information available in two distinct datasets. Given a batch of preprocessed blood cell images, our system performs two parallel inference operations:
Morphological Attribute Recognition: A ViT-based model, trained on the WBCAtt dataset [6], analyzes the input images to extract 11 fine-grained morphological attributes. These attributes include cell size, cell shape, nucleus shape, nuclear-cytoplasmic ratio, chromatin density, cytoplasm texture, cytoplasm color, cytoplasm vacuole, granularity, granule type, and granule color. The ViT architecture is particularly effective for this task due to its ability to model long-range dependencies and complex relationships between different cellular components through its self-attention mechanisms.
Cell Type Classification: Concurrently, a CNN model, trained on the larger PBC dataset [5], classifies the input images into one of eight cell types: neutrophils, eosinophils, basophils, lymphocytes, monocytes, immature granulocytes, erythroblasts, and platelets. The CNN architecture excels at capturing hierarchical features and local patterns critical for cell type differentiation.
The outputs from both models are combined to create a comprehensive 12-attribute characterization of each blood cell image. This integration mimics the holistic assessment process used by clinical pathologists, who consider both cell type and morphological characteristics when making diagnostic decisions.
III-B Datasets Used
III-B1 Description of the Datasets
Our study relies on two complementary WBC image sets.
PBC [5] — 17,092 May Grünwald-Giemsa–stained single-cell images (360 × 363 px, JPG) captured by a CellaVision DM96 from healthy donors. They cover eight classes: neutrophils (3,329), eosinophils (3,117), basophils (1,218), lymphocytes (1,214), monocytes (1,420), immature granulocytes
(2,895), erythroblasts (1,551) and platelets (2,348). We use them to train the CNN cell-type classifier.
WBCAtt [6] — 10,298 images annotated with 11 expert-defined morphological attributes, spanning cell and nucleus size/shape, N:C ratio, chromatin density, cytoplasm texture / colour / vacuoles, and granule presence, type and colour (see Fig. 2). These labels drive the ViT model for fine-grained attribute recognition.
III-B2 Preprocessing Steps
PBC Dataset Preprocessing: We developed a robust preprocessing pipeline for the PBC dataset. First, we standardized images by resizing them to 224224 pixels, converting them to NumPy arrays, and normalizing pixel values between [0–1] for stable gradient computations during training. Furthermore, we converted textual labels into numerical values and applied one-hot encoding, making them suitable for CNN-based multi-class classification while maintaining categorical relationships.
WBCAtt Dataset Preprocessing: We performed advanced preprocessing for the multi-attribute WBCAtt dataset. Initially, CSV files with image paths and attribute annotations were loaded. Attributes were standardized through alphabetically sorted bijective mappings between textual labels and numeric encodings. Images were resized to 224224 pixels, normalized, and converted to tensors. Data were serialized into dictionaries with preprocessed images and encoded labels. This streamlined pipeline enhanced model performance and training efficiency.
III-B3 Data Splits
We applied standardized dataset splits for robust evaluation. The PBC dataset was divided into 80% training (13,673 images), 10% validation (1,710 images), and 10% test data (1,709 images), ensuring balanced representation. For the WBCAtt dataset, splits comprised approximately 60% training (6,179 images), 10% validation (1,030 images), and 30% test data (3,099 images), effectively capturing attribute variations and enabling thorough performance assessment.
III-B4 Data Augmentation
PBC Dataset Augmentation:
-
•
Shear Transformation set to 0.3 to introduce shape distortions.
-
•
Zoom set to 0.3 for simulating scale variations.
WBCAtt Dataset Augmentation for VIT based models:
-
•
Random Horizontal Flip to enhance orientation diversity.
-
•
Resize (256 pixels, maintaining aspect ratio) along with Center Crop (224×224 pixels) for standardized evaluation.
WBCAtt Dataset Augmentation for CNN Model:
-
•
Random Crop (224×224 pixels) to improve generalization by focusing on different image regions.
-
•
Random Horizontal Flip to enhance robustness through orientation variations.
III-C Models Used
Our AttriGen framework leverages specialized deep learning architectures for the distinct tasks of cell type classification and morphological attribute recognition.
Cell Type Classification: For classifying blood cells into eight types, we implemented the VGG16 architecture [20] pre-trained on ImageNet and fine-tuned on the PBC dataset. VGG’s hierarchical convolutional structure effectively captures the local features and spatial patterns critical for distinguishing between different cell types.
Architectures for Attribute Recognition: We evaluated multiple CNN and ViT architectures, selecting the following best performing models:
-
•
VGG16 [20]: A CNN known for strong feature extraction and excellent performance in visual recognition tasks.
-
•
ViT-B/16 [21]: Utilizes 16×16 image patches processed through transformer encoders to effectively capture global cell relationships.
-
•
Swin-S [22]: Features hierarchical shifted-window structures enabling efficient multi-scale feature extraction.
-
•
DeiT-B [23]: Employs knowledge distillation for efficient yet high-performance training.
-
•
DeiT-S [23]: Compact, parameter-efficient variant suitable for resource-constrained scenarios.
III-D Results
III-D1 PBC Results
| Papers | Methods Used | Accuracy (%) |
|---|---|---|
| [24] | Custom CNN-based Framework | 99.91 |
| [25] | Multibranch Lightweight CNN | 99.72 |
| [26] | Attention-based Data Augmentation (EfficientNet) | 99.69 |
| [27] | SC-MP-Mixer (Swin Transformer + ConvMixer) | 99.65 |
| [28] | R-CNN + CNN Classification | 99.31 |
| [29] | BloodCaps (Capsule Network) | 99.30 |
| [30] | Modified Inception-based CNN | 98.89 |
| Our Model | VGG16 | 98.83 |
| [31] | BCNet (Transfer Learning + Ensemble) | 98.51 |
| [32] | ShuffleNet-based CNN | 97.94 |
The Table I shows comparative results on PBC dataset. Although our model did not achieve the global benchmark, as obtaining the highest possible accuracy was not the primary focus of our study, it still demonstrated strong performance, reaching an accuracy of 98.83%. This result highlights the effectiveness and potential of our proposed methodology within the scope of the research.
III-D2 Metrics Used
To evaluate the performance of our classification model across multiple attributes, we utilized five key evaluation metrics:
Predefined Metrics:
-
•
Accuracy (): Measures the proportion of correctly classified samples out of the total samples.
-
•
Precision (): Represents the proportion of correctly predicted positive samples out of all predicted positives.
-
•
Recall (): Also known as sensitivity or true positive rate, it quantifies the proportion of actual positive samples that were correctly predicted.
-
•
F1-score (): A harmonic mean of precision and recall, providing a balance between the two metrics.
Global Average Accuracy (GAA): To provide a holistic evaluation across multiple attributes, we define a GAA metric. This is computed by averaging the accuracy values across all attribute heads:
| (1) |
where is the total number of attribute heads, and is the accuracy of the attribute head. This metric ensures that the overall performance of the model across different attributes is effectively represented.
Unlike previous studies that employed metrics such as AUC [15] or ACAcc[14], we chose GAA due to its straightforward interpretability and its capacity to equally weigh each attribute prediction without bias toward any specific attribute class.
III-D3 WBCAtt Results
| Authors | Methods Used | GAA(%) |
| Our Model | Swin-S | 94.62 |
| Our Model | ViT-B/16 | 94.35 |
| Our Model | DeiT-B | 94.31 |
| Our Model | DeiT-S | 94.19 |
| Our Model | VGG16 | 91.42 |
| [33] | Morphological Attributes Predictor (MAP) | 88.65 |
The Table II shows comparative results on WBCAtt dataset. Our Swin-S model established a new global benchmark by achieving a GAA of 94.62%.
III-D4 Results Comparison
| Attribute | Accuracy (%) | Precision (%) | Recall (%) | F1 Score (%) |
|---|---|---|---|---|
| Cell Size | 84.03 | 84.02 | 84.03 | 83.99 |
| Cell Shape | 94.29 | 94.40 | 94.29 | 94.33 |
| Nucleus Shape | 80.51 | 80.69 | 80.51 | 80.34 |
| Nuclear-Cytoplasmic Ratio | 98.61 | 98.60 | 98.61 | 98.60 |
| Chromatin Density | 94.93 | 94.71 | 94.93 | 94.79 |
| Cytoplasm Vacuole | 97.58 | 97.59 | 97.58 | 97.59 |
| Cytoplasm Texture | 96.55 | 96.65 | 96.55 | 96.58 |
| Cytoplasm Colour | 95.58 | 95.60 | 95.58 | 95.57 |
| Granule Type | 99.61 | 99.61 | 99.61 | 99.61 |
| Granule Colour | 99.29 | 99.29 | 99.29 | 99.29 |
| Granularity | 99.81 | 99.81 | 99.81 | 99.81 |
| Global Average | 94.62 | 94.63 | 94.62 | 94.59 |

Among the tested models on WBCAtt Dataset, Swin-S achieved the highest accuracy at 94.62% (Table II), closely followed by other ViT variants, confirming the effectiveness of transformer-based models in attribute recognition tasks. VGG16, with an accuracy of 91.42%, demonstrated impressive performance considering its lower computational demand, making it suitable for efficiency-focused scenarios. All five models surpassed previous benchmarks, underscoring their robust performance across different computational requirements.
Table III provides a detailed breakdown of Swin-S’s performance across different attributes. The model performed exceptionally well in recognizing Granularity, Granule Type, and Granule Colour, achieving near-perfect accuracy (99.81%, 99.61%, and 99.29%, respectively). These results suggest that transformer-based models can effectively capture fine-grained cellular features.
Attributes like Nuclear-Cytoplasmic Ratio (98.61%) and Cytoplasm Vacuole (97.58%) also showed high classification performance, indicating that the model is adept at distinguishing nuclear and cytoplasmic characteristics. However, Nucleus Shape (80.51%) and Cell Size (84.03%) had relatively lower accuracy, suggesting room for improvement in learning shape-related morphological variations.
To better understand the decision-making process of Swin-S, we employed Grad-CAM visualization, as shown in Figure 3. This highlights the most important regions in the image that contributed to the model’s predictions, allowing for better interpretability of the attribute classification results.
III-E AttriGen
Our dual-model architecture demonstrates strong performance in both cell type classification and morphological attribute recognition tasks. However, the broader application of such attribute-based approaches in medical image analysis remains constrained by a critical limitation: the scarcity of comprehensively annotated datasets. The WBCAtt dataset exemplifies this challenge, as its creation involved a meticulous and labor-intensive annotation process. Specifically, biomedical students initially annotated over 10,000 WBC images, each with 11 morphological attributes. Subsequently, research scientists meticulously reviewed each image and its assigned attributes, ensuring that every image was inspected by at least two individuals. Ambiguities were resolved through discussions with pathologists. This complex process is both time-consuming and costly, as it requires specialized domain knowledge, making the creation of large-scale multi-attribute datasets prohibitively expensive [6]. This data bottleneck represents a significant obstacle to advancing interpretable AI systems in hematological diagnosis and similar medical domains. It is imperative to explore more efficient and scalable annotation methods to overcome these challenges?
III-E1 Proposed Approach
To address the challenges associated with manual annotation of WBC images, we introduce AttriGen, an automated system designed to efficiently and accurately annotate multi-attribute datasets. Considering the PBC dataset, which comprises 17,092 images, manually annotating each image would be a formidable task. In contrast, applying our solution to the remaining 6,784 unannotated cells in the PBC dataset at a rate of 20 milliseconds per cell would result in approximately 2.26 minutes, a considerable improvement in efficiency. This automated approach not only accelerates the annotation process but also minimizes the reliance on specialized domain knowledge, thereby reducing costs and facilitating the development of large-scale, comprehensively annotated datasets.
III-E2 AttriGen: Framework Architecture

As illustrated in Figure 4, AttriGen follows a bootstrapping approach that begins with a small expert-labeled dataset containing multi-attribute annotations. This seed dataset trains a ViT model that undergoes rigorous evaluation against human expert performance. Through iterative refinement, the model achieves near-human-level accuracy, at which point it becomes qualified to generate trusted annotations for previously unlabeled images. This process creates a substantially expanded dataset with comprehensive multi-attribute labels at a fraction of the time and cost of manual annotation.
III-E3 AttriGen: Impact on Computer Vision
AttriGen advances cell microscopy analysis in several key dimensions. First, it democratizes access to richly annotated datasets, enabling researchers without extensive annotation resources to develop and validate attribute-based recognition systems. Second, it facilitates the exploration of complex relationships between morphological attributes and disease states that would otherwise remain unexamined due to data limitations. Finally, while demonstrated in hematological image analysis, the AttriGen approach establishes a generalizable paradigm for expanding attribute-based image classification datasets across diverse medical imaging domains, potentially accelerating the development of more interpretable and clinically relevant computer vision systems throughout healthcare.
IV Conclusion
This paper introduces AttriGen, a novel framework for automated multi-attribute annotation in computer vision, with particular focus on blood cell microscopy. By creating a dual-model architecture that combines a CNN and ViT, our approach achieves 94.62% GAA on multi-attribute classification while establishing a new paradigm for efficient dataset annotation. The integration of two complementary datasets; PBC for cell type classification and WBCAtt for morphological attributes, enables comprehensive 12-attribute characterization (11 attributes + cell type) aligned with real-world clinical assessment protocols.
Our automated approach demonstrates remarkable time efficiency, reducing annotation time for 6,784 images to approximately 2.26 minutes compared to extensive manual effort that would require weeks. The performance gap of 1.48% between AttriGen (94.62%) and human experts (96.1%) is a reasonable trade-off given the enormous time savings necessary in scenarios where rapid analysis of large datasets is prioritized. Additionally, our framework used high-quality seed datasets (WBCAtt and PBC) for initial training, and validation with pathological samples achieving clinical robustness. Future research should explore extension to pathological cells with abnormal morphologies, which are critical for leukemia and other hematologic disease diagnosis. Additionally, active learning techniques could further optimize the annotation process, and enhanced explainability methods could highlight influential image regions for specific predictions.
References
- [1] J. A. B. Bispo, P. S. Pinheiro, and E. K. Kobetz, “Epidemiology and etiology of leukemia and lymphoma,” Cold Spring Harbor Perspectives in Medicine, vol. 10, no. 6, p. a034819, 2020.
- [2] B. J. Bain, “Diagnosis from the blood smear,” New England Journal of Medicine, vol. 353, no. 5, pp. 498–507, 2005. [Online]. Available: https://www.nejm.org/doi/full/10.1056/NEJMra043442
- [3] A. Fayyaz, B. Khalid, M. U. Tariq, M. Javed, and S. Gul, “The critical shortage of medical laboratory professionals: A global crisis with major implications,” Biomedical Journal of Scientific & Technical Research, vol. 53, no. 2, pp. 40 182–40 188, 2023. [Online]. Available: https://biomedres.us/fulltexts/BJSTR.MS.ID.008604.php
- [4] A. Acevedo et al., “Recognition of peripheral blood cell images using convolutional neural networks,” Computer Methods and Programs in Biomedicine, vol. 180, p. 105020, 2020.
- [5] A. Acevedo, A. Merino, S. Alférez, Ángel Molina, L. Boldú, and J. Rodellar, “A dataset of microscopic peripheral blood cell images for development of automatic recognition systems,” Data in Brief, vol. 30, p. 105474, 2020. [Online]. Available: https://www.sciencedirect.com/science/article/pii/S2352340920303681
- [6] S. Tsutsui et al., “Wbcatt: A white blood cell dataset annotated with detailed morphological attributes,” in Advances in Neural Information Processing Systems, vol. 36, 2023.
- [7] H. K. Walker, W. D. Hall, and J. W. Hurst, Eds., Clinical Methods: The History, Physical, and Laboratory Examinations, 3rd ed. Butterworths, 1990. [Online]. Available: https://www.ncbi.nlm.nih.gov/books/NBK263/
- [8] A. V. Hoffbrand and P. A. Moss, Essential haematology. John Wiley & Sons, 2019.
- [9] D. M. Sabino et al., “A texture approach to leukocyte recognition,” Real-Time Imaging, vol. 10, no. 4, pp. 205–216, 2004.
- [10] N. M. Salem, “Segmentation of white blood cells from microscopic images using k-means clustering,” in 2014 31st National Radio Science Conference (NRSC), 2014, pp. 371–376.
- [11] S. K. Mondal, M. S. H. Talukder, M. Aljaidi, R. B. Sulaiman, M. M. S. Tushar, and A. A. Alsuwaylimi, “Bloodcell-net: A lightweight convolutional neural network for the classification of all microscopic blood cell images of the human body,” 2024. [Online]. Available: https://arxiv.org/abs/2405.14875
- [12] C. H. Lampert et al., “Learning to detect unseen object classes by between-class attribute transfer,” in 2009 IEEE Conference on Computer Vision and Pattern Recognition. IEEE, 2009, pp. 951–958.
- [13] V. Cheplygina et al., “Not-so-supervised: A survey of semi-supervised, multi-instance, and transfer learning in medical image analysis,” Medical Image Analysis, vol. 54, pp. 280–296, 2019.
- [14] J. Feng, Q. Guo, S. Luo, L. Chen, and Q. Ma, “Blood cell attribute classification algorithm based on partial label learning,” Electronics, vol. 13, no. 9, 2024. [Online]. Available: https://www.mdpi.com/2079-9292/13/9/1698
- [15] Y. Nie, S. He, Y. Bie, Y. Wang, Z. Chen, S. Yang, and H. Chen, “Conceptclip: Towards trustworthy medical ai via concept-enhanced contrastive langauge-image pre-training,” 2025. [Online]. Available: https://arxiv.org/abs/2501.15579
- [16] G. Litjens et al., “A survey on deep learning in medical image analysis,” Medical Image Analysis, vol. 42, pp. 60–88, 2017.
- [17] R. M. Tayebi, Y. Mu, T. Dehkharghanian, C. Ross, M. Sur, R. Foley, H. R. Tizhoosh, and C. J. Campbell, “Histogram of cell types: Deep learning for automated bone marrow cytology,” 2021. [Online]. Available: https://arxiv.org/abs/2107.02293
- [18] K. Sohn, D. Berthelot, C.-L. Li, Z. Zhang, N. Carlini, E. D. Cubuk, A. Kurakin, H. Zhang, and C. Raffel, “Fixmatch: Simplifying semi-supervised learning with consistency and confidence,” 2020. [Online]. Available: https://arxiv.org/abs/2001.07685
- [19] J. Tremblay, A. Prakash, D. Acuna, M. Brophy, V. Jampani, C. Anil, T. To, E. Cameracci, S. Boochoon, and S. Birchfield, “Training deep networks with synthetic data: Bridging the reality gap by domain randomization,” 2018. [Online]. Available: https://arxiv.org/abs/1804.06516
- [20] K. Simonyan and A. Zisserman, “Very deep convolutional networks for large-scale image recognition,” 2015. [Online]. Available: https://arxiv.org/abs/1409.1556
- [21] A. Dosovitskiy et al., “An image is worth 16x16 words: Transformers for image recognition at scale,” in International Conference on Learning Representations, 2021.
- [22] Z. Liu, Y. Lin, Y. Cao, H. Hu, Y. Wei, Z. Zhang, S. Lin, and B. Guo, “Swin transformer: Hierarchical vision transformer using shifted windows,” 2021. [Online]. Available: https://arxiv.org/abs/2103.14030
- [23] H. Touvron et al., “Training data-efficient image transformers & distillation through attention,” in International Conference on Machine Learning. PMLR, 2021, pp. 10 347–10 357.
- [24] R. Asghar, S. Kumar, P. Hynds, and A. Mahfooz, “Classification of all blood cell images using ml and dl models,” 2023. [Online]. Available: https://arxiv.org/abs/2308.06300
- [25] H. Fırat, “Classification of microscopic peripheral blood cell images using multibranch lightweight cnn-based model,” Neural Computing and Applications, vol. 36, no. 4, pp. 1599–1620, 2024. [Online]. Available: https://doi.org/10.1007/s00521-023-09158-9
- [26] N. Bayat, D. D. Davey, M. Coathup, and J.-H. Park, “White blood cell classification using multi-attention data augmentation and regularization,” Big Data and Cognitive Computing, vol. 6, no. 4, 2022. [Online]. Available: https://www.mdpi.com/2504-2289/6/4/122
- [27] H. Üzen and H. Fırat, “A hybrid approach based on multipath Swin transformer and ConvMixer for white blood cells classification,” Health Information Science and Systems, vol. 12, no. 1, p. 33, 2024.
- [28] H. Atıcı and H. E. Kocer, “Mask R-CNN based segmentation and classification of blood smear images,” Global Journal of Engineering Sciences, vol. 9, no. 1, pp. 128–143, 2023.
- [29] F. Long, J. Peng, W. Song, X. Xia, and J. Sang, “BloodCaps: A capsule network based model for the multiclassification of human peripheral blood cells,” Computer Methods and Programs in Biomedicine, vol. 202, p. 105972, 2021.
- [30] H. Fırat, “Modifiye edilmiş inception modülü kullanılarak İnsan periferik kan hücrelerinin Çoklu sınıflandırılması,” Mühendislik Bilimleri Ve Araştırmaları Dergisi, vol. 5, no. 2, pp. 272–284, 2023.
- [31] C. Chola, A. Y. Muaad, M. B. Bin Heyat, J. V. B. Benifa, W. R. Naji, K. Hemachandran, N. F. Mahmoud, N. A. Samee, M. A. Al-Antari, Y. M. Kadah, and T. S. Kim, “BCNet: A deep learning computer-aided diagnosis framework for human peripheral blood cell identification,” Diagnostics, vol. 12, no. 11, p. 2815, 2022.
- [32] F. Ucar, “Deep learning approach to cell classificatio in human peripheral blood,” in 2020 5th International Conference on Computer Science and Engineering (UBMK), 2020, pp. 383–387.
- [33] Y. Chen, Z. Chen, Y. An, C. Lu, and X. Qiao, “Daffnet: A dual attention feature fusion network for classification of white blood cells,” ArXiv, vol. abs/2405.16220, 2024. [Online]. Available: https://api.semanticscholar.org/CorpusID:270063959